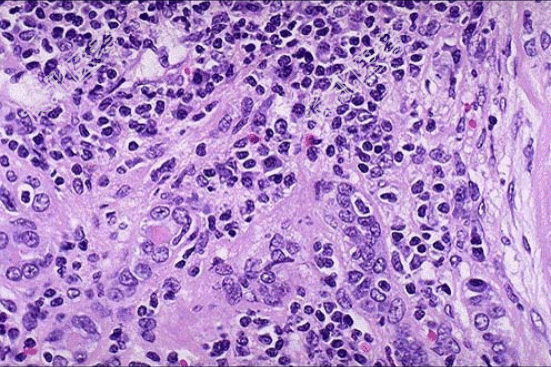

试题详情
- [材料题] 患者女性,53岁,双肾缩小,表面可见不规则瘢痕,两侧改变不对称,切开,皮髓质界限不清,肾乳头萎缩,肾盏和肾盂因瘢痕收缩而变形,肾盂黏膜粗糙;巨检如图,镜下如图所示。
- 简答题1、应首先考虑的是?
关注下方微信公众号,搜题查看答案

- 简答题2、该疾病需与哪些疾病进行鉴别诊断?
关注下方微信公众号,搜题查看答案

热门试题
- 1、最可能的诊断是?2、该疾病的镜下改变
- 1、该疾病病理学表现为?2、该疾病病免疫
- 1、免疫组织化学角蛋白、EMA、钙视网膜
- 1、该疾病好发于哪个年龄段?2、该疾病好
- 1、该疾病镜下改变表现为?2、该疾病免疫
- 1、其病理诊断为?2、该疾病好发于?3、
- 1、该疾病好发于哪个年龄段?2、该疾病可
- 1、最先怀疑的疾病是?2、该疾病的病因包
- 1、该疾病诊断时要注意哪几点?2、该疾病
- 1、该疾病多数发生于?2、该疾病肉眼与镜
- 1、镜检如图所示黏膜内大量炎细胞浸润,以
- 1、该疾病光镜检查表现为?2、该疾病需与
- 1、该患者最可能的诊断是什么?2、该疾病
- 1、该疾病的病因为?2、该疾病肉眼改变表
- 1、本病可发于?2、本病肉眼改变可有哪些
- 1、该疾病的镜下改变表现为?2、该疾病免
- 1、该疾病大体检查表现为?2、该疾病组织
- 1、应诊断为?2、该疾病的病因包括?3、
- 1、该疾病的病因是?2、该病属于大叶肺炎
- 1、发病部位最常见于?2、该疾病的肉眼改